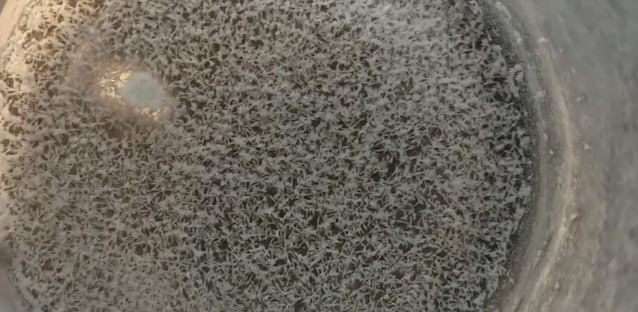

Se facessimo evaporare un litro d’acqua, sul fondo rimarrebbe una sottile polvere bianca: è il cosiddetto residuo fisso, composto da sali minerali e da tracce di metalli pesanti. Proprio questi ultimi – piombo, mercurio, cadmio e altri – sono al centro delle analisi chimiche che, come potete vedere dal video, garantiscono la sicurezza dell’acqua che beviamo ogni giorno.
L’acqua, prima di arrivare nei rubinetti o di essere imbottigliata, scorre tra rocce e terreni, arricchendosi di elementi presenti nella crosta terrestre. Oltre ai sali minerali utili al nostro organismo, può quindi contenere anche metalli non essenziali (non servono a nulla per il nostro organismo) come arsenico, piombo, mercurio, cadmio e nichel.
Questi elementi, seppur naturali, sono tossici anche a basse concentrazioni e tendono a bioaccumularsi negli organismi viventi. Per questo motivo, è molto molto importante che le acque destinate al consumo umano abbiano una concentrazione di questi elementi sotto un certo livello: finché le quantità restano sotto soglia, l’acqua è sicura. Come sempre, è la dose che fa il veleno.
Ma come facciamo ad essere sicuri che la loro concentrazione sia sufficientemente bassa? Con le analisi chimiche. Infatti, se prendiamo l’etichetta di qualsiasi acqua in bottiglia possiamo notare che ci sono tantissimi dati come: pH, conducibilità, residuo fisso e poi ci sono tutta una serie di valori che indicano la concentrazione di sodio, calcio, magnesio, potassio, cloruri, fluoruri, carbonati, ecc. E i metalli pesanti?

Come si può vedere nel video, nel residuo fisso (ossia la quantità totale di sali minerali e oligoelementi disciolti in un litro d'acqua che rimane dopo l'evaporazione del campione a 180°C) ci sono anche metalli pesanti, ma in quantità così basse da non causare alcun tipo di danni. E per capire se la loro concentrazione è sotto il limite di legge, abbiamo bisogno di strumentazioni che funzionano grazie ad una tecnologia incredibile.
E questi strumenti vengono forniti da aziende specializzate come FKV, storico fornitore di strumentazione scientifica per analisi di laboratorio e partner di questo video.
Tutti i metalli vengono analizzati e quantificati con macchinari come quello che si vede nel video, uno spettrometro di massa a plasma accoppiato induttivamente, detto ICP-MS. Concettualmente è uno strumento in grado di capire la concentrazione di tutti gli ioni, inclusi quelli dei metalli pesanti con estrema sensibilità e precisione.

Il funzionamento di questo strumento è complesso, ma l’aspetto più interessante riguarda il plasma, un gas ad altissima temperatura (circa 8000 °C), una temperatura persino superiore a quella della superficie del Sole. A queste condizioni, i metalli perdono gli elettroni e diventano ioni, particelle cariche che possono essere identificate con grande precisione. In questo modo lo strumento fornisce dati estremamente accurati sulla concentrazione sia dei metalli pesanti sia degli ioni benefici come sodio, calcio e magnesio.
In Italia per fortuna le acque che scorrono nei nostri territori sono quasi prive di questi metalli, quindi ci sono ma in concentrazioni così basse da non essere un problema per noi.
Oltre allo spettrometro, nei laboratori si usano anche titolatori multiparametrici automatici, strumenti che misurano sostanze come cianuri, ammonio e parametri fondamentali come colore, pH e conducibilità. Grazie a queste tecnologie è possibile controllare con precisione la qualità dell’acqua, garantendo che quella del rubinetto o in bottiglia sia sicura da bere.